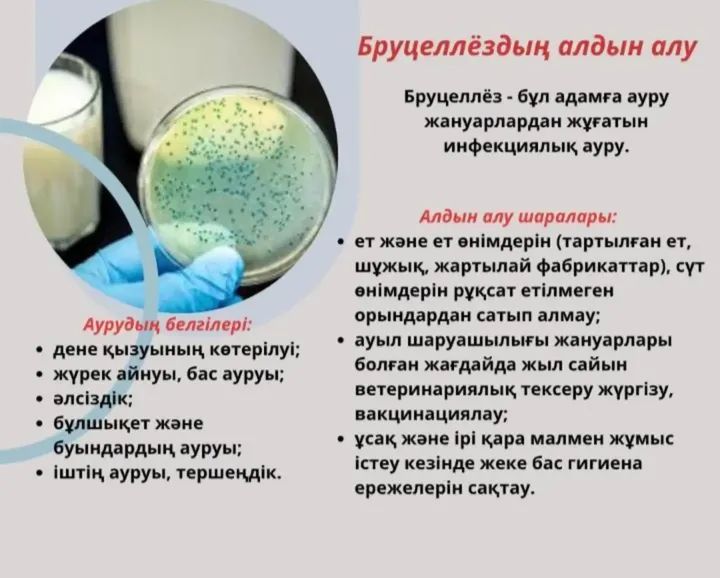
Бруцеллездің алдын алу

Бiздiң сайтымыздың құрметтi қонақтары!

Мен сіздерді «Солтүстік Қазақстан облысы әкімдігінің ветеринария басқармасы» коммуналдық мемлекеттік мекемесінің «Мағжан Жұмабаев ауданының ветеринариялық станциясы» шаруашылық жүргізу құқығындағы мемлекеттік коммуналдық кәсіпорнының сайтында көргеніме қуаныштымын! Біздің сайтымыз халықпен, жергілікті мемлекеттік басқару органдарымен, кәсіпкерлікпен және мал шаруашылығы саласындағы шағын орта бизнес субъектілерімен тиісті ынтымақтастық пен өзара іс-қимылды жолға қоюға толық ықпал ететініне, ақпарат алмасу процесін жеделдететініне және жетілдіретініне, сайтқа әрбір келушіге кәсіпорынның тарихы, оның қызметі мен көрсетілетін қызметтері туралы ақпарат алуға, мал шаруашылығы саласындағы қызықтыратын мәселелер, сондай-ақ Солтүстік Қазақстан облысы Мағжан Жұмабаев ауданының кәсіпорынды және жалпы барлық ветеринариялық қызметті үдемелі дамыту бойынша өз ұсыныстарын енгізу.
Кәсіпорынның заңды мекенжайы: 150800, Қазақстан Республикасы, Солтүстік Қазақстан облысы, Мағжан Жұмабаев ауданы, Булаев қаласы, Коморов көшесі, 8А н.т. 1.
«СҚО әкімдігінің ветеринария басқармасы» КММ «Мағжан Жұмабаев ауданының ветеринариялық станциясы» ШЖҚ МКК директордың м.а. Әбішев Азамат Әбілұлы
Байланыс 8 (71531) 2-15-94
Email: vetstanciya.mzh.sko@yandex.ru
Кәсіпорын Мағжан Жұмабаев ауданы әкімдігінің 2012 жылғы "20" ақпандағы № 75 қаулысына сәйкес құрылды.
Біздің кәсіпорынның басым бағыты – бұл ветеринарлық қызмет
Кәсіпорын қызметінің негізгі мақсаты Мағжан Жұмабаев ауданы аумағында ветеринариялық-санитариялық салауаттылықты қамтамасыз ету болып табылады.
Қойылған мақсатты іске асыру үшін кәсіпорын мынадай қызмет түрлерін жүзеге асырады:
1) Жануарлардың аса қауіпті, жұқпалы емес және энзоотиялық ауруларына қарсы ветеринариялық іс-шаралар жүргізу;
2) ауыл шаруашылығы жануарларын бірдейлендіруді жүргізу;
3) жануарларды қолдан ұрықтандыру бойынша қызметтер көрсету;
4) жануарлардың аса қауіпті және энзоотиялық ауруларына қарсы ветеринариялық препараттарды тасымалдау (жеткізу), сақтау, сондай-ақ ауыл шаруашылығы жануарларын бірдейлендіруді жүргізуге арналған бұйымдарды (құралдарды) және атребуттарды тасымалдау (жеткізу) бойынша қызметтер көрсету;
5) құрылысын тиісті әкімшілік-аумақтық бірліктердің жергілікті атқарушы органдары ұйымдастырған мал қорымдарын (биотермиялық шұңқырларды), мал сою алаңдарын (ауыл шаруашылығы жануарларын сою алаңдарын) күтіп-ұстау жатады;
6) ветеринариялық анықтамалар беру;
7) ауыл шаруашылығы жануарларын бірдейлендіру жөніндегі дерекқорды жүргізу және одан үзінді көшірмелер беру;
8) биологиялық материалдың сынамаларын алуды және оларды ветеринариялық зертханаға жеткізуді қамтиды:
9) Кәсіпорынның жарғысына сәйкес ауру жануарларды санитариялық союға тасымалдау бойынша қызметтер көрсету.